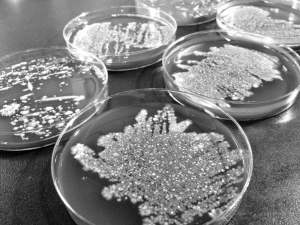
日本人真不吃三文鱼刺身？芥末 食醋 白酒 蒜泥 生姜谁真能杀菌？

蔡澜爆料说正统日料店三文鱼都是腌着吃?
送检的三文鱼、北极贝样品,检出大肠埃希菌、嗜盐弧菌等致病菌
“刺身”,原泛指一切可以生吃的肉类,因原料主要是海鱼,中国人常简称为“生鱼片”;在中国日料店的生鱼片里,“三文鱼刺身”是绝对的主打款,而在自助餐厅中,吃货们如果想“吃回本”、“扶墙进、扶墙出”,第一轮“扫荡”目标也绝对少不了它。
但最近,随着《舌尖上的中国Ⅱ》的热播,节目总顾问、美食家蔡澜在前年关于三文鱼的一段话又被拿到网上热议——
“正统的日本铺子,绝对不会卖三文鱼刺身,因为他们老早知道它的虫极多,只能用盐腌制过后烧熟来吃。”
“原来日本人自己不吃三文鱼”,不少吃货看到后,纷纷表示情何以堪。事实真是这样吗?口说无凭,实验为证。
日本人真不生吃三文鱼?
当然不是。
“我对三文鱼有偏见,觉得有阵不愉快的味道,所以绝不会吃。”虽然蔡澜先生很讨厌三文鱼,但却从没说过“日本人不吃三文鱼刺身”,这其实是网友们的断章取义;事实上,在《三文鱼》一文中,蔡澜先生还特意讲到三文鱼刺身在日本的畅销——
“至于我们爱吃的三文鱼刺身,各家旋转寿司和日本超市均有出售,连城中高级寿司铺也摆着。”
但作为一个顶级美食家,蔡澜先生确实多次强调这样一种品位和观点——在最正统的日本寿司铺里,不会有三文鱼刺身卖,理由是“日本人叫三文鱼为鲑Shake,多是用盐腌过,切成片,当中餐煎来吃。”
这个,蔡澜先生搞错了,他文中提到的三文鱼其实并不是一个概念。三文鱼并不特指某一种鱼,而是鲑科鱼类或鲑鳟鱼类的总称。
“鲑shake”在日语中主要是指“白鲑”,是野生捕捞的,易有寄生虫,所以在日本一直是熟食、忌生吃,当然也就不会在传统寿司铺做成刺身。
而“各家旋转寿司和超市均有出售三文鱼刺身”,是指英语中salmon三文鱼,主要是挪威等地养殖的大西洋三文鱼,这种刺身料理,对日本来说,也是新近的舶来品。
杭州木木亭日本料理店的店主李晟,在日本留学、工作10年,他说,日本人不生吃三文鱼,是早些年前的事了。
“当时三文鱼基本都是野生的,寄生虫会从它们吃的小鱼小虾里,感染到鱼身上。但后来三文鱼采用养殖的方式,寄生虫问题就不严重了。”
53岁的宫肋洋,是土生土长的日本人,在浙江工业大学外国语学院做外教。他也说,20年前日本人吃三文鱼的人确实很少,就是怕寄生虫。
此外就是口味的喜好。
宫肋洋说,在传统的日本刺身中,鲷鱼、金枪鱼一直最受欢迎,也很贵,而三文鱼刺身和煎三文鱼是最近几年才流行起来的。
“日本的高级日料店,以关西最多,但关西人的口味整体偏爱白生鱼,而不是三文鱼那样的红生鱼,所以在关西的高级日料店里,即便是蓝鳍金枪这样的顶级红生鱼也卖得不多。”李晟说。
目前,日本用于生吃的三文鱼几乎都来自挪威。《好奇实验室》从挪威海产局总部了解到,2009—2011年,日本进口的整条冰鲜三文鱼,挪威的占到87%,2011年—2013年,挪威出口日本的冰鲜三文鱼鱼柳(用来作为刺身食用),分别是3477吨、5548吨、7405吨。
两种三文鱼 吃法各不同
三文鱼盛产在挪威、芬兰和美国阿拉斯加。国内常见的挪威三文鱼和阿拉斯加三文鱼,它们保鲜方式、口感都有不同——
挪威三文鱼属大西洋鲑鱼,用海水大网箱人工养殖,大多是空运到中国,一般在0—4℃中保鲜,进入市场后以冰鲜方式出售。
挪威海产局大中华区总监毕思明说,冰鲜的挪威三文鱼不会因为解冻而影响肉质,此外,养殖的三文鱼肉质肥厚,捕获后短时间内就送上餐桌,适合生吃做刺身。
而美国阿拉斯加三文鱼是太平洋鲑鱼。美国阿拉斯加海产市场协会工作人员姚军说,阿拉斯加立法规定,包括三文鱼在内的所有海产,养殖是犯法的,所以都是野生捕捞,然后在船上急冻到-20℃,来保证鲑鱼的新鲜,再加上海运到中国,所以市面上大多以冰冻的方式出售。
“如果现捞现吃,都可以做刺身,人工饲养的挪威三文鱼肉质肥美,野生的阿拉斯加三文鱼紧实有韧性。而多了储存运输过程后,挪威三文鱼是冰鲜,口感上做刺身更适合,冷冻的阿拉斯加三文鱼更多拿来熟吃。”杭州中策职业学校西餐组教研组长沈俊文说,不同产地的三文鱼,颜色也有差别。挪威三文鱼呈现鲜明的橙红色,鱼肉上有清晰的白色条纹,而阿拉斯加三文鱼鱼肉呈深红色,白色条纹比较浅。
“如果是粉色的,有可能是虹鳟鱼冒充的。”沈俊文说,虹鳟鱼34块钱一斤,而三文鱼一般在50-60元/斤。两者外表有差别,三文鱼一般在一米以上,市场需求一般以4-6公斤为多,而虹鳟鱼要小得多,个头在40厘米左右,重量也就8斤左右。但切开后的鱼肉就难分辨了,口感也差不多,不懂的人很容易上当。
刺身上有哪些寄生虫和致病菌?
既然是生吃,寄生虫和致病菌肯定是首要考量。
每个进入中国的国外海产品,都必须按照国家质检总局《进出口水产品检验检疫监督管理办法》进行检验检疫。2013年,杭州质检口岸共进境三文鱼45批,122.4吨。浙江出入境检验检疫局杭州机场办事处的林瀑说,检测项目有致病性微生物、重金属、农兽药残留等,去年,杭州空港口岸就销毁过一批检出单增李斯特菌的三文鱼。
《好奇实验室》随机买了5份三文鱼,送到杭州市疾控中心,结果没有检出携带寄生虫。
杭州市疾控中心地防所所长徐卫民说,样本太少,难下定论,但按以往调查看,海鱼身上寄生虫要比淡水鱼少,但也不能避免,比较常见的是异尖线虫。
舟山市疾控中心曾经对东海海鱼中异尖线虫的感染情况进行调查,总感染率为49.1%,其中带鱼、海鳗等鱼类的感染率超过90%。而日本已报道人体感染异尖线虫病例14000多例,是世界之最。
“异尖线虫,长30—90毫米,宽0.5毫米,肉眼虽然可见,但由于通体白色,很容易被忽视。”徐所长说,海洋中的贝、鱼的内脏、鱼肉上都会存在异尖线虫,感染后会出现剧烈的腹痛和过敏等反应。
徐所长说,杭州还没有发现吃三文鱼感染异尖线虫的病例,但是,这种寄生虫病跟普通腹痛的病状很像,所以不排除误诊可能。
《好奇实验室》又在超市买了三文鱼、北极贝两种刺身,送到浙江省人民医院检验科进行致病菌检测。
取样过程在无菌室内完成,所使用的刀具和砧板也经杀菌消毒,48小时后的结果是——
三文鱼上的菌落是320cfu/g,而北极贝上的菌落密密麻麻、难以数清,检测人员估计应该超过20万cfu/g。
浙江省人民医院检验科副主任吕火烊说,检查出来的有常见的大肠埃希菌、粪肠球菌、枯草芽孢杆和一些革兰阳性的杆菌,其中大部分细菌对人体没什么危害。但大肠埃希菌,可能造成食物中毒,引起腹泻腹痛。北极贝发现的嗜盐弧菌,存在于深海,它存活能力强,在抹布和砧板上能生存1个月以上,也会引起急性的食物中毒。
“这些细菌也可能是在加工运输过程中被污染的。”吕医生说,“如果保存不善,细菌繁殖起来,就更危险了。”
芥末 食醋 白酒 蒜泥 生姜
能杀死寄生虫和致病菌吗?
吃刺身,首选调料是芥末和酱油,像中国的呛虾,更有白酒、醋、蒜泥、姜葱。
那么,这些调料能杀死食材中的寄生虫吗?
2001年延边大学医学院发表的《简单异尖线虫幼虫对调味品、抗蠕虫药和中药的耐受试验》,异尖线虫能在食醋中存活105小时,在高浓度白酒中存活24分钟,蒜泥汁中存活7小时,生姜汁中10小时。
2006年宁波市疾控中心发表的《东海鱼类异尖线虫感染调查及其幼虫对青芥辣的耐受研究》,在芥末溶液中浸泡55分钟才能完全杀死异尖线虫和它的幼虫。
这样看,呛虾还好,因为有高浓度白酒浸泡,半小时的浸泡时间也还能接受,但说要吃个刺身先在芥末里浸泡55分钟就闻所未闻了。
“最有效的办法就是在70℃下加热4-5分钟,但刺身是生吃,惟一的办法就只有低温冷冻,-18℃下48小时,或者-20℃下2小时,也能杀死寄生虫。”杭州市疾控中心地防所所长徐卫民说。
野生三文鱼的寄生虫,主要来自它们吃的小鱼小虾,所以野生的阿拉斯加三文鱼采用的是-20℃冷冻保存和运输,这对异尖线虫这些寄生虫有非常好的杀灭作用。而挪威三文鱼虽然是0—4℃冰鲜保存,但因为是人工养殖,从食物链上最大程度避免寄生虫的感染。
除了寄生虫,刺身上还有致病菌,通过实验,《好奇实验室》发现,这些调料的杀菌效果同样不理想。

杀菌效果最好的是白酒;而生姜因本身大量带菌,不但没起到杀菌作用,菌落总数反而增加。
《好奇实验室》又将实验升级,验证这些调料对金黄色葡萄球菌、大肠埃希菌、铜绿假单胞菌、奇异变形杆菌这4种常见的致病菌的杀菌效果。
结果,只有白酒能做到完全杀死致病菌,醋、芥末、蒜泥抑菌效果都不理想。
需说明的是,实验中病菌与白酒充分接触了10分钟,而餐桌上是蘸着就吃,杀菌效果会大打折扣。
“靠调料来把细菌杀灭,几乎不可能。”浙江省人民医院检验科副主任吕火烊说,这时,我们只能靠最后一道防线——胃酸。
吕医生说,正常人的胃液可以杀死80%—90%的细菌,但如果常吃带菌食物,细菌多了就会形成抱团聚集,这时胃酸液就无法全部杀死它们了。